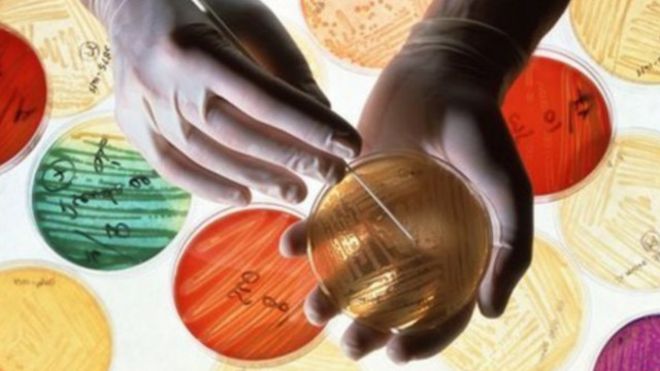

وكالات
طالبت أكثر من 80 شركة أدوية الحكومات بابتكار طرق جديدة لتمويل أبحاث تطوير المضادات الحيوية.
ونشرت الشركات بيانا مشتركا في المنتدى الاقتصادي العالمي، قالت فيه إن قيمة المضادات الحيوية “لا تعكس فوائدها للمجتمع”.
وفي المقابل، وعدت الشركات بالاستثمار في الأبحاث، وتحسين طرق الحصول على المضادات الحيوية حول العالم.
ومن بين المشاركين في البيان شركات جي إي كي، وميرك، وفايزر، وجونسون آند جونسون.
وكانت التحذيرات قد تكررت من أن العالم على حافة “عصر ما بعد المضادات الحيوية”، مما يثير احتمال العدوى غير القابلة للعلاج. وهو ما يشكل خطرا على العمليات الجراحية وعلاجات السرطان التي تعتمد على المضادات الحيوية.
ومن المتوقع أن تتسبب الميكروبات المقاومة للعقاقير في قتل عشرة ملايين شخص في العالم بحلول 2050، وخسارة مئة ترليون دولار من المنتج الاقتصادي.
فشل
لكن على مدي أكثر من أربعة عقود، لم تُطرح أنواع جديدة من المضادات الحيوية في السوق.
وذكر البيان أن الطريقة المتبعة حاليا “فشلت تماما” رغم استثمار مليارات الدولارات. وأشار إلى التحديات العلمية “المذهلة” التي دفعت العديد من شركات الأدوية إلى الانسحاب من البحث في المضادات الحيوية.
وأحد أكبر التحديات الآن هو الأموال، إذ تتلقى الشركة أجرا مقابل مبيعاتها من العقاقير فقط.
لكن أي مضاد حيوي حديث يُستخدم كحل أخير، مما يعني أن الشركات لن تتلقى مقابل لتكلفة البحث.
سداد فوري
وأشار تقرير نشره الاقتصادي جيم أونيل إلى ضرورة سداد مبالغ مالية لشركات الأدوية لتطوير مضادات حيوية جديدة. وقدر تكلفة مشاركة الحكومات بحوالي 16-37 مليار دولار خلال العقد القادم.
وقال رئيس شركة أسترا زينيكا، باسكال سوريوت: “الصناعات على استعداد للتعاون مع الحكومات لتطوير آليات بديلة للسوق لتحقيق استثمار طويل الأمد، وهو أمر ضروري إذا أردنا التغلب على التحديات التقنية والعلمية المذهلة التي تواجه اكتشاف وتطوير المضادات الحيوية”.
وكانت رئيسة منظمة الصحة العالمية، مارغريت تشان، قد قالت: “مقاومة الجراثيم للمضادات الحيوية تتعدى قدرة أي منظمة أو دولة للتعامل معها بشكل منفرد. وتناشد المنظمة والدول الأعضاء تطوير مضادات حيوية جديدة، ويمكن الوصول إليها بسهولة، تماشيا مع خطة العمل العالمية للتعامل مع مقاومة الجراثيم للمضادات الحيوية. ويؤكد هذا البيان على أن التحديات التي تواجه الصناعة يمكن التعامل معها فقط عن طريق التكافل والتحرك الدولي الجماعي”.